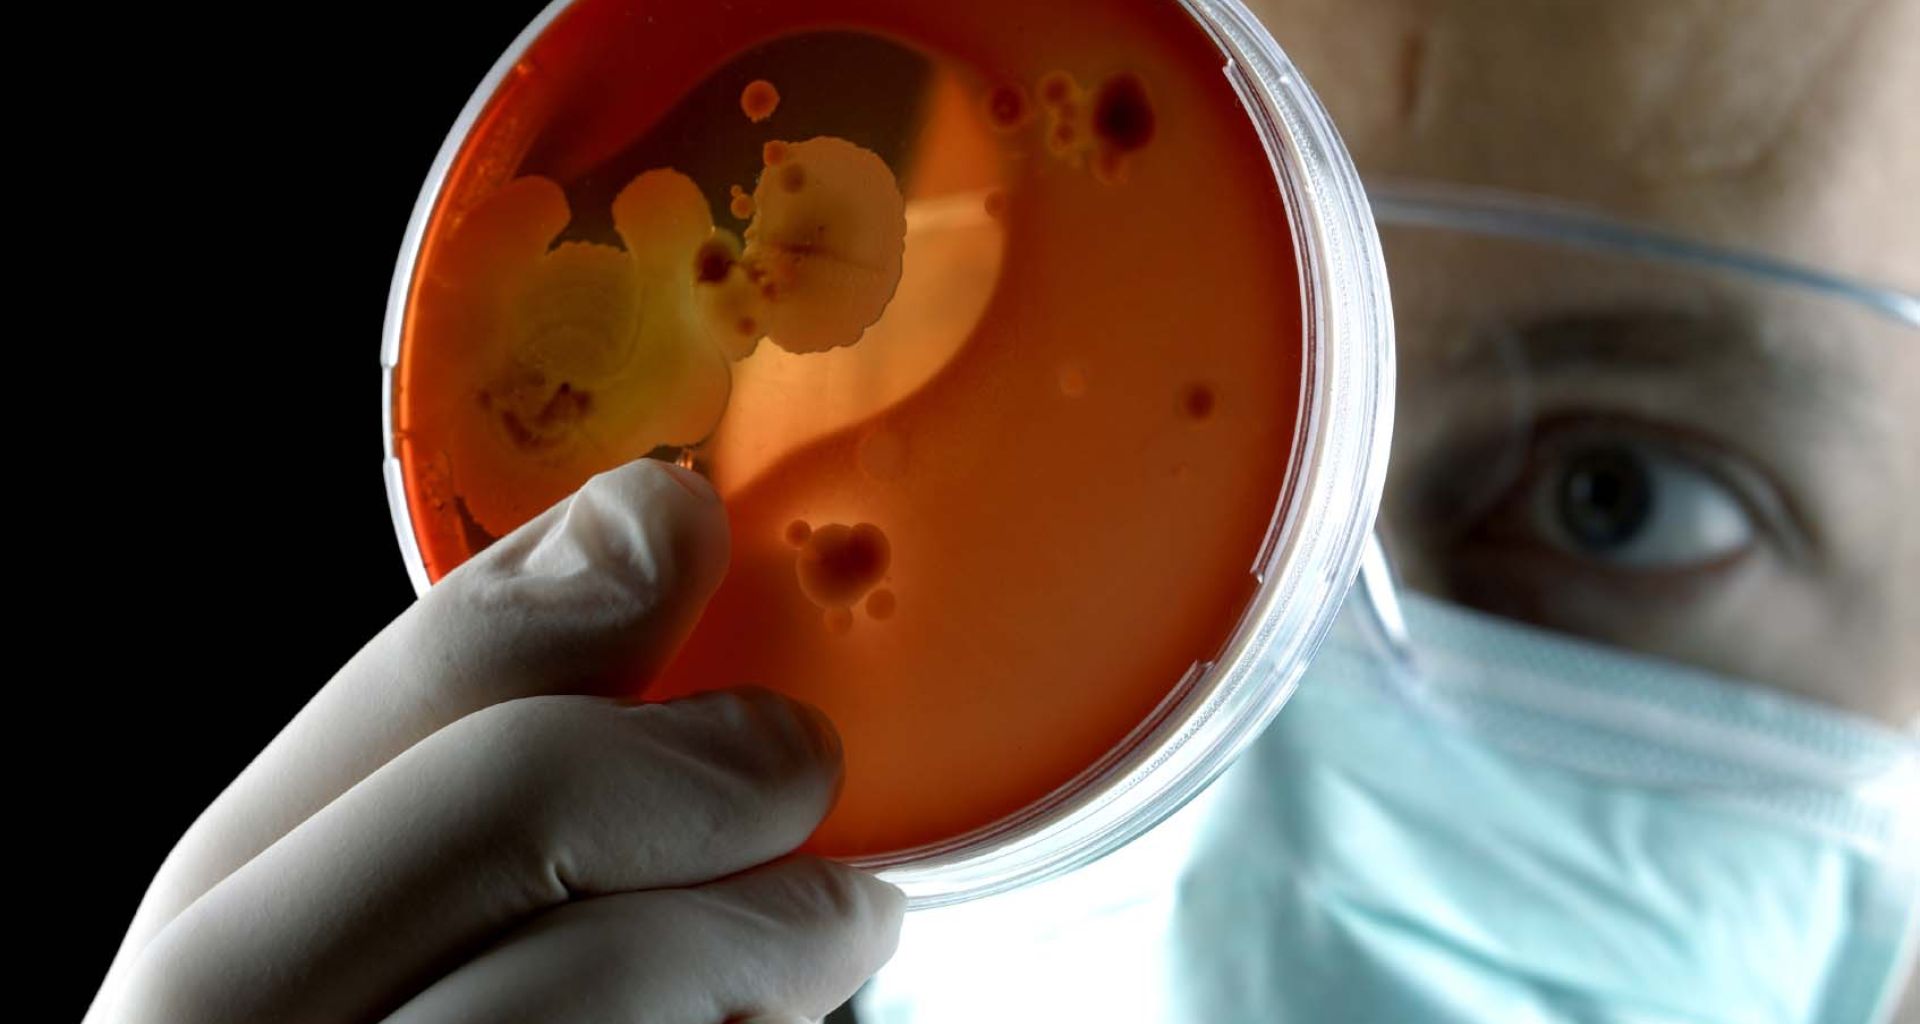
أجهزة الميكروويف لمعالجة النفايات الطبية الخطرة 3 أجهزة الميكروويف لمعالجة النفايات الطبية الخطرة

أجهزة الميكروويف لمعالجة النفايات الطبية الخطرة
تعتبر تقنية التعقيم بواسطة أستعمال أجهزة الميكروويف من الطرق التعقيم الحديثة للنفايات الطبية المتبعة في العديد من المستشفيات والمرافق الصحية، وهي مبنية في الأساس على التعقيم بالحرارة الرطبة بواسطة البخار الناتج عن طاقة الميكروويف. الميكرويف موجات قصيرة جدا في الطيف الكهرومغناطيسي. وهي تقع في نطاق الترددات الراديوية، فوق التردد العالي جدا (UHF) المستخدم للتلفزيون ويقع […]
تعتبر تقنية التعقيم بواسطة أستعمال أجهزة الميكروويف من الطرق التعقيم الحديثة للنفايات الطبية المتبعة في العديد من المستشفيات والمرافق الصحية، وهي مبنية في الأساس على التعقيم بالحرارة الرطبة بواسطة البخار الناتج عن طاقة الميكروويف.
الميكرويف موجات قصيرة جدا في الطيف الكهرومغناطيسي. وهي تقع في نطاق الترددات الراديوية، فوق التردد العالي جدا (UHF) المستخدم للتلفزيون ويقع أقل من نطاق الأشعة تحت الحمراء. ويستخدم المغنطرون (magnetron) وهو مولد موجات الميكروويف لتحويل الطاقة الكهربائية ذات الجهد العالي إلى طاقة الميكروويف، ثم ينتقل إلى قناة معدنية تدعى الدليل الموجي (waveguide) الذي يوجه الطاقة إلى منطقة معينة (مثل منطقة الطهي في فرن الميكروويف أو قسم المعالجة في وحدة التطهير).
وبصفة عامة، يتكون جهازة الميكروويف من منطقة تطهير وهي التي توضع فيها النفايات الطبية يتم فيها توجيه طاقة الموجات الميكروويف من مولد الميكروويف (magnetron). عادة، يتم استخدام 2 إلى 6 المغنطرون مع إخراج حوالي 1.2 كيلوواط لكل منهما. وقد صممت بعض النظم على أساس موجات ذات دفعات مستمرة والبعض الآخر موجات متقطعة. عدة شركات أوروبية نجحت في مجال صناعة أجهزة الميكروويف منها شركات إكوستيريل (Ecostéryl)، ميديستر (Medister)، سانيتيك (Sanitec)، سينتيون (Sintion)، ستيريفانت (Sterifant).
كيف تعمل أجهزة الميكروويف:
تشغيل وحدة الميكروويف كما يلي:
- تحميل وتعبئة النفايات الطبية: في البداية يتم تحميل أكياس النفايات الطبية الحمراء أو الصفراء في عربات مخصصة لجهاز الميكروويف قرب فتحة التغذية للجهاز في حجرة التعقيم. تم يتم حقن البخار الساخن جدا إلى حجرة التعقيم ويتم أستخراج الهواء من خلال فتحات بمصفيات (HEPA)، تم يتم رفع الأكياس ودفعها إلى حجرة التعقيم وإغلاق حجرة التعقيم.
- مرحلة التقطيع: بعد إغلاق حجرة التعقيم، يتم تحريك النفايات بواسطة دراع وتقطيعها إلى أجزاء صغيرة جدا حتى يتغلل البخار لكل الأجزاء في النفايات ويتم التعقيم بالكامل بواسطة آلة التقطيع (Shredder).
- معالجة المايكروويف: يتم نقل الجسيمات التي تم تمزيقها عن طريق اللولب الناقل الدوار حيث تتعرض للبخار ثم تسخن إلى ما بين 95 درجة مئوية و 100 درجة مئوية بواسطة أربعة أو ستة مولدات الميكروويف.
- الوقت المستغرق للتعقيم: يضمن قسم الحيازة معالجة النفايات بمدة زمنية كافية لا تقل عن 30 دقيقة.
- تقطيع ثانوي اختياري: أحيانا يتم تمرير النفايات المعالجة من خلال جهاز تقطيع ثان يقطعها إلى قطع أصغر. وتستخدم هذه الطريقة عندما يتم التعامل مع النفايات الحادة. يمكن إرفاق التقطيع الثانوي الاختياري في حوالي 20 دقيقة قبل التشغيل. وهو يقع في نهاية اللولب الناقل الثاني.
- التفريغ: يتم نقل النفايات المعالجة باستخدام لولب ناقل ثان، مع أخذ النفايات من حجرة المعالجة وتفريغها مباشرة إلى الحاوية. يمكن بعدها نقل النفايات مباشرة إلى مكب صحي.

أنواع النفايات المعالجة في أجهزة الميكروويف:
النفايات التي تتم معالجتها عادة في أجهزة الميكروويف مماثلة لتلك التي يتم معالجتها في الأوتوكلاف: مثل أطباق المزارع البكتيرية والأدوات الحادة والمواد الملوثة بالدم وسوائل الجسم من قسم العناية الفائقة وحجرة العزل والأنعاش ونفايات العمليات الجراحية الجراحة ومخلفات مختبر التحاليل الطبية (باستثناء النفايات الكيميائية) والنفايات اللينة ( الشاش، الضمادات، الستائر، الملاءات، الفراش، الخ) من رعاية بالمرضى. مع ما يكفي من الوقت ودرجة الحرارة، فضلا عن الحركة الميكانيكية فيتم تعقيم النفايات وحتى يغير شكلها وقوامها. يمكن عبر الميكروويف تقنياً معالجة النفايات الباثولوجية البشرية (مثل المشيمة وألأطراف والأنسجة البشرية الناتجة من العمليات الجراحية) ولكن للاعتبارات الأخلاقية والقانونية والثقافية وغيرها من الاعتبارات تحول دون معالجتها. ويجب عدم معالجة الأتي في الميكروويف: المركبات العضوية المتطايرة وشبه المتطايرة، والنفايات العلاج الكيميائية، والنفايت الصيدلانية، والزئبق، والنفايات الكيميائية الخطرة الأخرى، والنفايات الإشعاعية.
الانبعاثات ومخلفات النفايات:
تعتبر الأنبعاتات الناتجة من معالجة النفايات الطبية بتقنية الميكروويف قليلة جدا إذا تم فرز النفايات قبلها بطريقة صحيحة ولم تحتوي على النفايات الكيميائية، وان هذه التقنية بصفة عامة تعتبر إنبعاتاتها في أدنى حد. كم ذكرت دراسة بأنها لم تجد مركبات عضوية متطايرة في المجال الجوى المحيط بأجهزة الميكروويف خلال عمليات المعالجة.
النشاط الميكروبي وأجهزة الميكروويف:
أثبتت العديد من الدراسات العلمية الميكروبيولوجية فعالية تقنية أجهزة الميكروويف في معالجة والقضاء على العديد من الجراثيم الضارة سوء جراثيم بكتيرية وفطرية وفيروسية وانواع عدة من الطفيليات مثل: Bacillus subtilis, Pseudomonas aeruginosa, Staphlococcus aureus, Enterococcus faecalis, Nocardia asteroides, Candida albicans, Aspergillus fumigatus, Mycobacterium bovis, Mycobacterium fortuitum,
المميزات والعيوب أجهزة الميكروويف:
مزايا تقنية الميكروويف:
- لأن العديد من الناس لديهم أفران الميكروويف في بيوتهم، فمن السهل لموظفي المستشفى والمجتمعات المحلية فهم وقبول التكنولوجيا.
- تم قبولها أو الموافقة عليها كتقنية بديلة لمعالجة النفايات الطبية فقد تم تشغيل عدة عشرات من الوحدات ولسنوات عديدة
- إذا اتخذت الاحتياطات المناسبة لاستبعاد المواد الكيميائية الخطرة من النفايات الطبية المعالجة، فإن الانبعاثات الصادرة عن أجهزة الميكروويف تكون ضئيلة.
- يقلل التقطيع الداخلي من حجم النفايات حتى 80٪.
- التقنية في الجهاز آلية وسهلة الاستخدام. يتطلب لتشغيلها فقط عامل واحد.
عيوب تقنية الميكروويف:
- أذا أحتوت النفايات الطبية المعالجة على كيماويات سامة ولم يتم فرزها وفصلها، فهذه السموم ربما تنطلق للهواء الجوي المحيط وربما تبثى في النفايت بعد المعالجة وتلوث التربة في حالة ردمها.
- توجد بعض الروائح الغير مرغوبة خارجة من وحدة المعالجة بالميكروويف.
- توجد ضوضاء من آلة التقطيغ الثانية المستعملة لتقطيع النفايات الحادة من الإبر والحقن.
- أي جسم حديدي صلب يكون مختلط من النفايات ربا يسبب في تكسير آلة التقطيع.
- تعتبر أجهزة التعقيم بالميكروويف مكلفة مادياً.
تحتوي بعض أجهزة الميكروويف على مزايا إضافية منها:
- بعض الأجهزة تحتوي على مصفيات من الفحم لتقليل من الروائح الكريهة التي تكون عادة مصاحبة لعملية التعقيم.
- بعض الأجهزة تحتوي على رذاذ للمطهرات في حجرة تعبئة النفايات وآلة شفط سوائل لتنظيف وتطهير مداخل النفايات. ولتعقيم السوائل الخارجة من وحدة المعالجة إلى مياه الصرف الصحي.
- بعض الشركات تقوم بتصنيع عدة أحجام لتناسب كميات النفايات الطبية
- بعض الأنواع من أجهزة الميكروويف ذات فعلية كبيرة تستطيع القضاء على الأنواع الخطيرة من المواد شديدة العدوى (highly infectious material).
- بعض الشركات تصنع في أجهزة ميكروويف متنقلة لسهولة نقلها حسب الحاجة في حمالات التطعيم وفي حالات حدوث الأوبئة والحالات الطارئة.
References:
Klaus Zimmermann. (2017). Microwave as an emerging technology for the treatment of biohazardous waste: A mini-review. Waste Management & Research. 2017, Vol. 35(5) 471–479.
Microwaves ecofriendly alternative for a safe treatment of medical waste. (2012). MEDWASTE Deliverable Action 1.3. Review regarding the technological, environmental and economical aspects of the new proposed medical waste treatment method
Non-Incineration Medical Waste Treatment Technologies A Resource for Hospital Administrators, Facility Managers, Health Care Professionals, Environmental Advocates, and Community Members August 2001. Health Care Without Harm

اترك تعليقاً